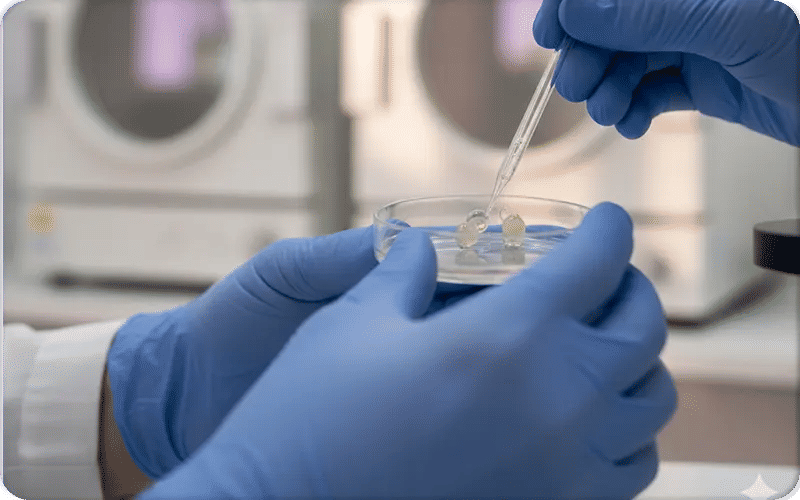
What Happens After Egg Retrieval?

- What Happens After Egg Retrieval?
- Recovery After Egg Retrieval
- Common Symptoms After Egg Retrieval
- Pain After Egg Retrieval and When to Seek Your Doctor
- What Happens to Ovaries After Egg Retrieval
- What Happens to Follicles After Egg Retrieval
- What Happens to Hormones After Egg Retrieval
- Egg Fertilization and Embryo Development in the Lab
- Start Your IVF Journey with Turkey Luxury Clinics Today
- FAQs About what Happens After Egg Retrieval
Egg retrieval is a crucial step in the IVF process, preceded by hormone injections that stimulate the ovaries to produce multiple eggs for retrieval. After the procedure, many women ask themselves: What happens next?
The next stage involves fertilization of the eggs, followed by embryo culture, genetic testing if chosen. The final step is embryo transfer into the uterus, followed by the waiting period until the pregnancy test is positive or your next menstrual cycle begins.
This is what happens after egg retrieval in relation to your eggs’ journey—but what about your body? After the procedure, your ovaries and follicles start recovering, and you may experience mild side effects resembling PMS. Some symptoms result from the procedure itself, while others are due to the injected hormones.
Recovery usually takes 2 to 7 days, after which you prepare for the embryo transfer as the lab confirms the embryo is ready.
At Turkey Luxury Clinics, we guide you through each step after egg retrieval. Contact us to book a consultation and receive a personalized plan with full support and expert guidance.
What Happens After Egg Retrieval?
After egg retrieval, your eggs are sent to the laboratory for fertilization with sperm or for freezing, while you recover at home from sedation and may notice mild cramping or light spotting.
Immediately after the egg retrieval procedure, your body may experience common side effects such as bloating, cramping, fatigue, and light spotting. Your ovaries, temporarily enlarged from stimulation, gradually return to their normal size, while hormone levels decline and stabilize.
Because the injected fertility medications reset your body’s natural hormones, your period may come later than expected compared to previous cycles.
You will usually need to rest for the day and have someone drive you home, and the next steps you discuss with your IVF team include monitoring embryo development, a possible transfer within a few days, and scheduling a pregnancy test about two weeks later.
Recovery After Egg Retrieval
Recovery after egg retrieval involves resting for at least 24-48 hours, managing mild cramping and bloating with heat and OTC meds, avoiding strenuous activity for about a week, and listening to your body as most symptoms resolve within days to a week, though ovaries take 1-2 weeks to normalize, with full recovery often by the next cycle.

Immediate Recovery (First 24-48 Hours)
- Rest is Key: Stay home and rest; you'll be drowsy from anesthesia.
- Manage Discomfort: Use a heating pad and over-the-counter pain relievers (like NSAIDs if approved by your doctor) for cramping and soreness.
- Light Activity Only: Gentle walking is fine, but avoid heavy lifting, bending, twisting, or strenuous exercise.
- Hydration & Diet: Drink plenty of fluids and eat a healthy diet; be mindful of constipation.
- No Driving: You must have someone drive you home.
Mid-Term Recovery (Days 3-7)
- Gradual Return to Activity: Most people feel well enough to return to light work and normal routines within a couple of days.
- Symptom Improvement: Bloating and discomfort usually decrease daily.
- Avoid Overexertion: Continue to avoid high-impact activities and heavy lifting to protect your ovaries.
Full Recovery (1-2 Weeks)
- Ovary Size: Your ovaries typically need one to two weeks to return to their normal size.
- Normal Routine: By the one-week mark, many people feel completely back to normal.
- Next Period: Your next menstrual cycle usually arrives within one to two weeks, signaling a return to natural rhythms.
Common Symptoms After Egg Retrieval

Cramping & Pain
After egg retrieval, common symptoms include mild to moderate cramping, similar to the discomfort associated with period pain. This occurs due to ovarian swelling following extensive stimulation, and the pain can be more noticeable when a large number of eggs are collected.
Pain after egg retrieval usually subsides within a few days. It should not make you wary or afraid, yet it may temporarily bother you or affect your quality of life. It improves within 24-48 hours, with most feeling back to normal in a few days to a week, though ovaries take 1-2 weeks to fully shrink and your doctor may prescribe analgesics such as acetaminophen or NSAIDs like diclofenac to help you feel more comfortable.
Bloating & Fatigue
Symptoms such as bloating, fatigue, and abdominal tenderness are common after egg retrieval. These result from ovarian enlargement and the stimulation medications used during the IVF cycle. Staying hydrated, resting, and avoiding strenuous activity can help ease these symptoms.
Spotting & Nausea
Light vaginal spotting or mild nausea is also common after egg retrieval. Spotting usually comes from the needle puncture site and should resolve within a day or two. Mild nausea may result from sedation or hormonal changes.
All symptoms usually subside within a few days as the ovaries gradually return to normal size and function.
Pain After Egg Retrieval and When to Seek Your Doctor
| Type of Pain | Cause | What to Do |
| Ovary Pain | Normal, from ovarian stimulation and swelling | Usually self-resolving; rest & hydrate |
| Chest Pain | Could indicate OHSS or fluid accumulation | Call your doctor immediately |
| Pelvic Pain | Normal after ovarian stimulation | Monitor; usually mild |
| Cramps | From ovary stimulation and hormones | Self-care; pain relief as prescribed |
| Bloating | Hormonal changes and ovarian stimulation | Hydrate; mild discomfort is normal |
| Upper Abdominal Pain | Post-procedure inflammation; possible OHSS | Call your doctor if severe |
| Severe Pain | May indicate OHSS or infection | Seek urgent medical attention |
| Stabbing Pain | Needle insertion and empty follicles | Usually short-term; monitor |
When Should You Consult Your Doctor for Pain After Egg Retrieval?
You should see a doctor if pain after egg retrieval is severe, keeps worsening, or is not relieved by the prescribed medications, particularly when it is accompanied by concerning symptoms such as fever, heavy bleeding (soaking a pad within an hour), persistent vomiting, shortness of breath, decreased urination, or rapid weight gain of about 2–3 pounds per day.
Signs like chills or foul-smelling vaginal discharge may indicate an infection and require immediate evaluation to rule out ovarian hyperstimulation syndrome (OHSS) or other post-procedure complications.
Ovarian Hyperstimulation Syndrome (OHSS) after egg retrieval happens when fertility meds overstimulate ovaries, causing swelling and fluid leakage, ranging from mild (bloating, mild pain) to severe (rapid weight gain, extreme pain, breathing issues).
What Happens to Ovaries After Egg Retrieval

Ovaries stimulation before egg retrieval:
IVF injections cause ovaries to grow larger as they stimulate multiple egg follicles, leading to common effects like bloating, pelvic fullness, and discomfort, but in some cases, this overstimulation results in Ovarian Hyperstimulation Syndrome (OHSS, requiring close monitoring and potentially different protocols.
What happens to ovaries after egg retrieval
After egg retrieval, your ovaries remain enlarged and sensitive, causing bloating, cramping, and soreness as they shrink back to normal size over several weeks, often with a period occurring about 10-14 days later if no pregnancy occurs, while hormones reset.
Ovaries' healing and recovery after egg retrieval:
Ovary healing after egg retrieval involves resting for 24-48 hours, managing cramping and bloating with pain relief and heat, and gradually returning to light activities, with full recovery (ovaries returning to normal size) taking about 1-2 weeks, though most feel normal sooner; avoiding strenuous activity, heavy lifting, and sex for at least a week is crucial to prevent complications like ovarian torsion.
What Happens to Follicles After Egg Retrieval

After egg retrieval, the follicles are essentially emptied of their eggs and fluid, and they typically collapse and shrink, eventually being reabsorbed by the body, follicles in your ovaries can follow three main scenarios:
- Collapse & Reabsorption: Once the fluid and eggs are aspirated from a follicle during egg retrieval, the follicle structure collapses because its main contents are gone.
- Natural Regression: Similar to unfertilized follicles after natural ovulation, these collapsed structures are gradually reabsorbed by the body over time.
- Not All Follicles Release Eggs: Normally, not every follicle contains a mature egg—some may be empty or produce immature eggs that cannot be fertilized.
What Happens to Hormones After Egg Retrieval
Before egg retrieval, your hormone levels are elevated due to fertility medications and injections. These high hormone levels contribute to the symptoms you may feel, such as bloating, cramping, and mood changes. After egg retrieval, the stimulating hormones drop rapidly, causing a temporary “hormone crash” that can mimic menopausal symptoms, including hot flashes and mood swings.
If no embryo transfer occurs, your period may be delayed by about two weeks as your natural cycle resets.
This first cycle after retrieval may also have a heavier flow or spotting. In cases where embryos are being transferred, progesterone supplementation may continue to support implantation and the early stages of pregnancy.
Egg Fertilization and Embryo Development in the Lab
What happens to eggs after egg retrieval? After your eggs are collected, the next step you will hear about is egg fertilization in the lab in IVF, either through conventional IVF, where your retrieved eggs and sperm are placed together in a petri dish to allow natural sperm penetration, or Intracytoplasmic Sperm Injection (ICSI), in which an embryologist selects a single healthy sperm and injects it directly into the cytoplasm of each mature MII egg.
This approach is often recommended when you are dealing with male-factor infertility or previous fertilization challenges.
Over the following days, your resulting embryos are carefully cultured and observed for development, and then one or more are transferred to your uterus when your body is ready, while any remaining viable embryos are frozen so you have future opportunities without repeating stimulation.

Stages after eggs retrieval include:
1. Egg & Sperm Collection: Mature eggs are retrieved, and your partner’s sperm sample is prepared in the lab.
2. Assessment: Embryologists examine the eggs to confirm the maturity stage and evaluate their quality.
3. Sperm Preparation: The sperm is processed to select the most motile and healthy cells for insemination.
4. Fertilization (IVF/ICSI): Mature eggs are either combined with sperm in a culture dish under in vitro conditions or injected with a single selected sperm using ICSI, depending on the diagnosis and treatment plan.
5. Incubation: The dishes are maintained overnight in optimal temperature, humidity, and pH-controlled conditions.
6. Day-1 Monitoring: Embryologists check for two pronuclei to confirm successful fertilization.
7. Embryo Culture: Embryos divide from Day 2 to Day 6 and typically reach the blastocyst stage by Day 5.
8. Cryopreservation: Eggs or embryos may be frozen through vitrification, a modern technique that prevents ice crystal formation and supports better survival for future cycles.
9. Fresh Embryo Transfer: You proceed to transfer the embryo into the uterus according to your agreed protocol.
Start Your IVF Journey with Turkey Luxury Clinics Today
Connect with top IVF specialists at world-class hospitals equipped with advanced labs and JCI accreditation. Receive personalized consultations, tailored all-inclusive packages, and expert guidance every step of the way. Your comfort and success are our priority—book your consultation now and take the first step toward achieving your dream of parenthood.
You may like
Positive Signs After Embryo Transfer: Early Pregnancy Clues
IVF Timeline: Step-by-Step Process from Start to Finish
How Successful is IVF? Success by Age, Cycles & Frozen Embryos
IVF After Tubal Ligation: Success Rates and Chances of Pregnancy












.webp)
.webp)
.webp)
.webp)

